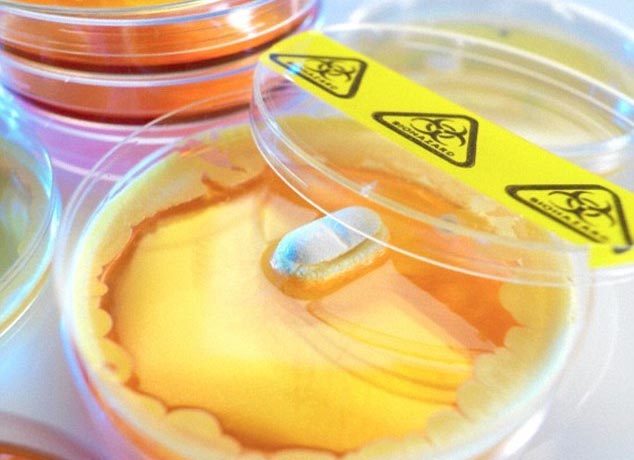
{keywords}

Các nhà nghiên cứu Mỹ vừa phát hiện một loại siêu kháng sinh có khả năng loại bỏ hầu hết các mầm bệnh, từ tụ cầu khuẩn vàng tới vi khuẩn lao, đang ẩn giấu trong đất.
Trong các thử nghiệm, loại thuốc kháng sinh mới đã nhanh chóng chữa trị được các nhiễm trùng có thể nguy hiểm chết người. Loại thuốc này cũng tỏ ra hữu hiệu trong việc chống lại các mầm bệnh khó tiêu diệt, gây tổn hại tim.
Điều quan trọng là, loại thuốc mới có thể là một vũ khí mạnh trong cuộc chiến chống lại hiện tượng kháng kháng sinh, trong đó, những nhiễm trùng từng dễ chữa trị hiện đã biến đổi thành dạng nguy hiểm chết người sau khi tìm được cách lẩn tránh các loại thuốc mạnh nhất.
Trước thực tế rằng không có loại thuốc kháng sinh mới nào trình làng trong gần 30 năm qua và các vi khuẩn hiện nay ngày càng khó tiêu diệt hơn, các chuyên gia từng cảnh báo, việc chữa trị y tế có thể sớm bị kéo giật lùi trở về tình trạng của thế kỷ 19.
Dame Sally Davies, một lãnh đạo Bộ Y tế Anh, thậm chí đã mô tả một "viễn cảnh tận thế" trong đó, chỉ sau 20 năm nữa, các phẫu thuật bình thường như thay khớp háng cũng có thể đe dọa tính mạng vì các nhiễm trùng tương đối nhỏ không còn dễ loại bỏ.
Loại thuốc kháng sinh mới, có tên teixobactin, được phát hiện sau khi các nhà khoa học Anh, Mỹ và Đức quay trở lại với những thứ căn bản và nghiên cứu về các vi khuẩn từ một đồng cỏ ở bang Maine, Mỹ.
Theo các chuyên gia, nhiều loại vi khuẩn và nấm tạo ra kháng sinh tự nhiên để giữ chúng an toàn và tiêu diệt đối thủ cạnh tranh thức ăn cũng như không gian. Hầu hết các kháng sinh chúng ta sử dụng ngày nay có nguồn gốc từ tự nhiên.
Tuy nhiên, với việc các vi trùng dễ nghiên cứu đã được tìm hiểu kỹ lưỡng và các vi khuẩn còn lại trong đất rất khó nuôi cấy trong phòng thí nghiệm, các nhà khoa học hiện đại gần như bỏ lỡ con đường nghiên cứu trên để theo đuổi các cách tiếp cận vận dụng công nghệ cao nhiều hơn.
Với quan điểm cho rằng, đất còn chứa đựng nhiều bí mật hơn nữa, các nhà nghiên cứu đến từ Đại học Tây Bắc ở Boston, Mỹ đã sáng chế ra một thiết bị cho phép họ nuôi dưỡng và nghiên cứu vi khuẩn trong đất. Trong số 10.000 loại vi khuẩn nuôi cấy, 25 chất chặt lọc được có tiềm năng sử dụng như thuốc kháng sinh và teixobactin tỏ ra có triển vọng nhất trong đó.
Trong các thí nghiệm trên chuột, ngoài việc tiêu diệt được hàng loạt loại vi khuẩn gây bệnh nguy hiểm, teixobactin còn làm được điều đó mà không gây ra các tác dụng phụ. Các chuyên gia đặc biệt phấn khích khi không thể sản sinh ra bất kỳ vi khuẩn nào có thể đề kháng lại sức mạnh của siêu thuốc kháng sinh mới.
Nhóm nghiên cứu tuyên bố, cơ chế hoạt động của teixobactin khiến các vi khuẩn rất khó tìm được cách vô hiệu hóa nó. Họ dự đoán, phải mất ít nhất 30 năm, các vi khuẩn may ra mới có thể phát triển được khả năng đề kháng loại thuốc này.
Các chuyên gia đang cải tiến công thức và hy vọng có có thể bắt đầu thử nghiệm thuốc ở người trong vòng 2 năm tới. Nếu mọi việc diễn ra tốt đẹp, teixobactin sẽ được sử dụng dưới dạng thuốc tiêm và có thể ra mắt thị trường vào năm 2019.
Tuấn Anh (Theo BBC, Daily Mail)